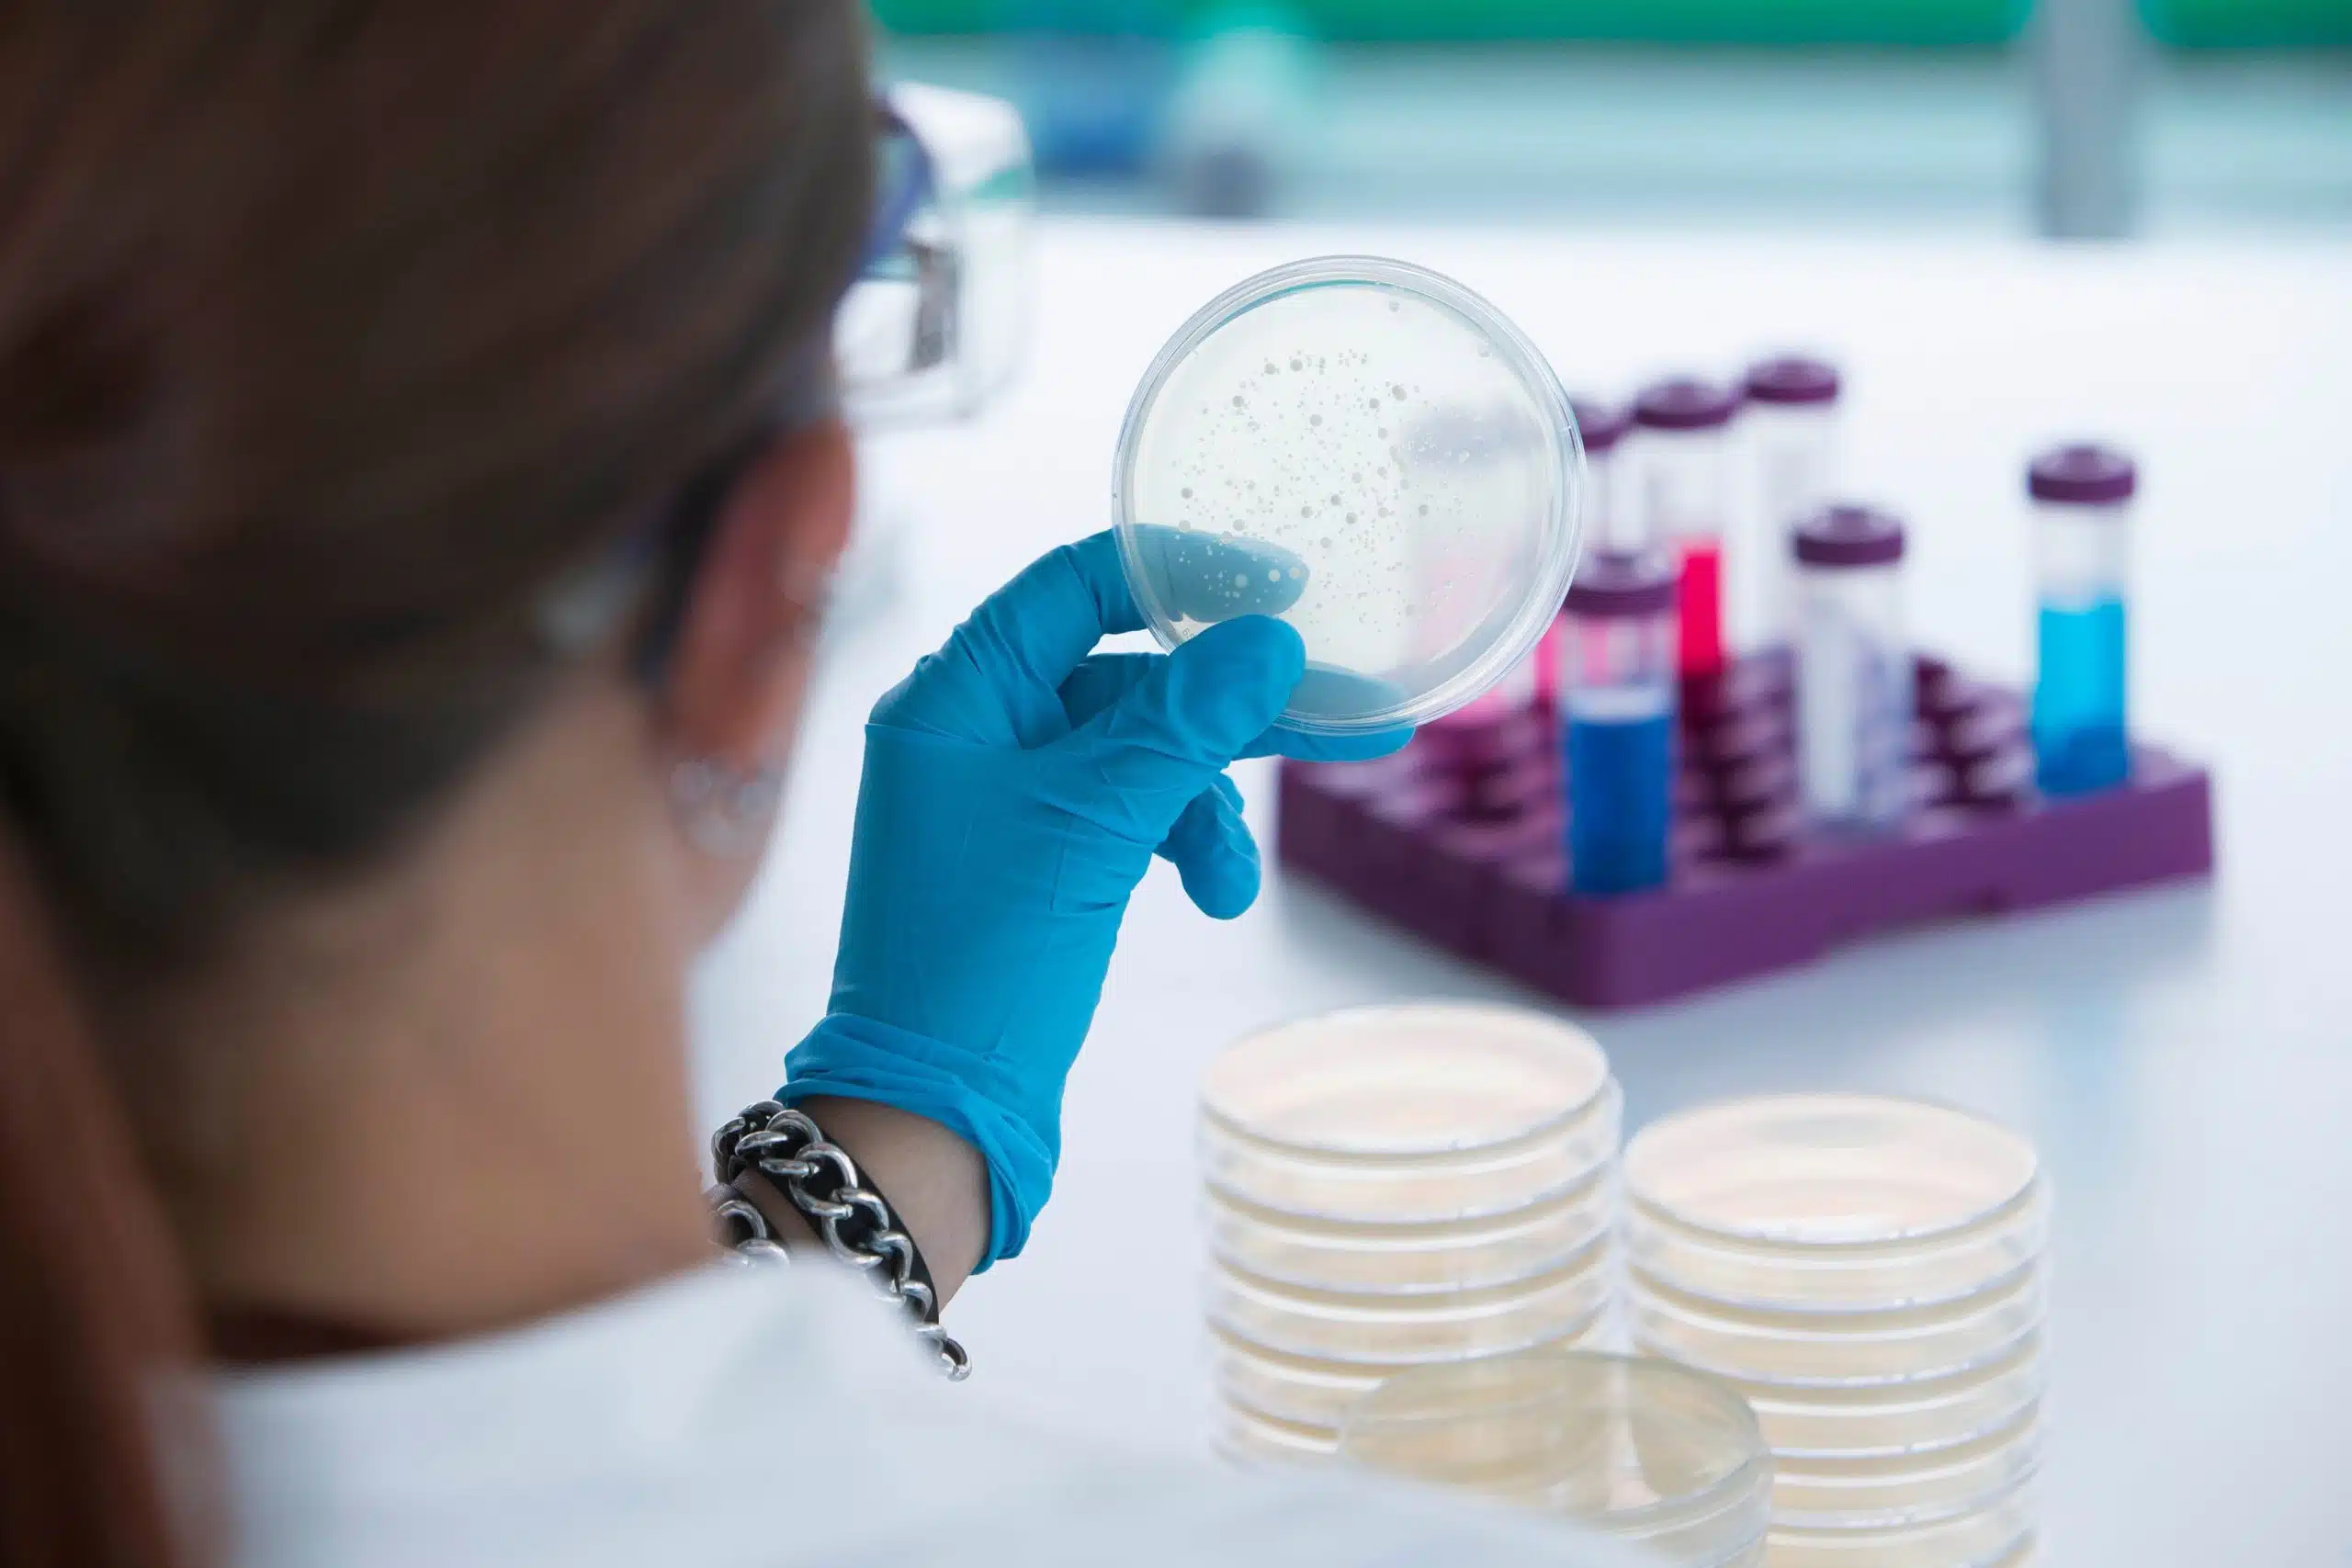

وبلاگ

تاثیر عوامل محیطی بر پایداری ایزوتیازولین ها
توجه: در این مقاله به جای کلمه ایزوتیازولینون از معادل رایج آن در محاوره “ایزوتیازولین” استفاده شده است. (برای خوانایی بهتر) نویسنده فراسبز آریاجم مقدمه

ایزوتیازولین چیست؟
ایزوتیازولین ترکیبی حیاتی در فرمول ها ایزوتیازولینون که در محاوره امروزه ایزوتیازین یا تیازین گفته می شود، یک ترکیب آلی است که از حلقه تیازول
قبل از خرید نگهدارنده بخوانید!
نگهدارنده ها موادی هستند که به محصولات آرایشی و بهداشتی اضافه می شوند تا از رشد و نمو میکروارگانیسم ها در محصول جلوگیری کنند. از

مکانیسم عملکرد برونوپل بر میکروارگانیسم ها
چکیده در این مقاله به تفاوت مواد باکتری ساید و باکتری استاتیک پرداخته می شود . عملکرد باکتری استاتیک برونوپل شرح داده می شود.

برونوپل چیست؟
ساختار و کاربرد برونوپل آنتی میکروبیال؛ نگهدارنده و ضدعفونی کننده ای موثر و بسیار کاربردی است. : 2-برومو2-نیترو1و3- پروپان دی ال یا برونوپل یک ماده

کاربرد تری اتانول آمین
کاربرد تری اتانول آمین تری اتانول آمین در هر نوع محصول خاص به خودی خود استفاده نمی شود، اما این ماده تثبیت کننده و تنظیم
